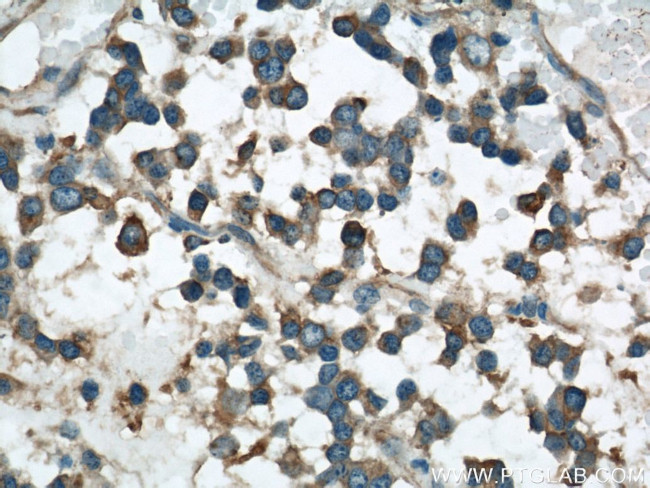
VAT1 Antibody in Immunohistochemistry (Paraffin) (IHC (P))

Search
Proteintech
VAT1 Polyclonal Antibody
{{$productOrderCtrl.translations['antibody.pdp.commerceCard.promotion.promotions']}}
{{$productOrderCtrl.translations['antibody.pdp.commerceCard.promotion.viewpromo']}}
{{$productOrderCtrl.translations['antibody.pdp.commerceCard.promotion.promocode']}}: {{promo.promoCode}} {{promo.promoTitle}} {{promo.promoDescription}}. {{$productOrderCtrl.translations['antibody.pdp.commerceCard.promotion.learnmore']}}
产品信息
22016-1-AP
种属反应
宿主/亚型
分类
类型
抗原
偶联物
形式
浓度
规格
纯化类型
保存液
内含物
保存条件
运输条件
产品详细信息
Immunogen sequence: MSDEREVAE AATGEDASSP PPKTEAASDP QHPAASEGAA AAAASPPLLR CLVLTGFGGY DKVKLQSRPA APPAPGPGQL TLRLRACGLN FADLMARQGL YDRLPPLPVT PGMEGAGVVI AVGEGVSDRK AGDRVMVLNR SGMWQEEVTV PSVQTFLIPE AMTFEEAAAL LVNYITAYMV LFDFGNLQPG HSVLVHMAAG GVGMAAVQLC RTVENVTVFG TASASKHEAL KENGVTHPID YHTTDYVDEI KKISPKGVDI VMDPLGGSDT AKGYNLLKPM GKVVTYGMAN LLTGPKRNLM ALARTWWNQF SVTALQLLQA NRAVCGFHLG YLDGEVELVS GVVARLLALY NQGHIKPHID SVWPFEKVAD AMKQMQEKKN VGKVLLVPGP EKEN (1-393 aa encoded by BC015041)
靶标信息
Synaptic vesicles are responsible for regulating the storage and release of neurotransmitters in the nerve terminal. The protein encoded by this gene is an abundant integral membrane protein of cholinergic synaptic vesicles and is thought to be involved in vesicular transport. It belongs to the quinone oxidoreductase subfamily of zinc-containing alcohol dehydrogenase proteins.
仅用于科研。不用于诊断过程。未经明确授权不得转售。
生物信息学
蛋白别名: FLJ20230; membrane protein of cholinergic synaptic vesicles; MIB; Mitofusin-binding protein; NADPH-dependent quinone oxidoreductase VAT1; similar to Pacific ray VAT1 protein, Swiss-Prot Accession Number P19333; Synaptic vesicle membrane protein VAT-1 homolog; unnamed protein product; VAT-1; VATI; Vesicle amine transport 1; vesicle amine transport protein 1 homolog (T californica); vesicle amine transport protein 1 homolog (T. californica)
基因别名: VAT-1; VAT1; VATI
UniProt ID: (Human) Q99536, (Rat) Q3MIE4, (Mouse) Q62465
Entrez Gene ID: (Human) 10493, (Rat) 287721, (Mouse) 26949